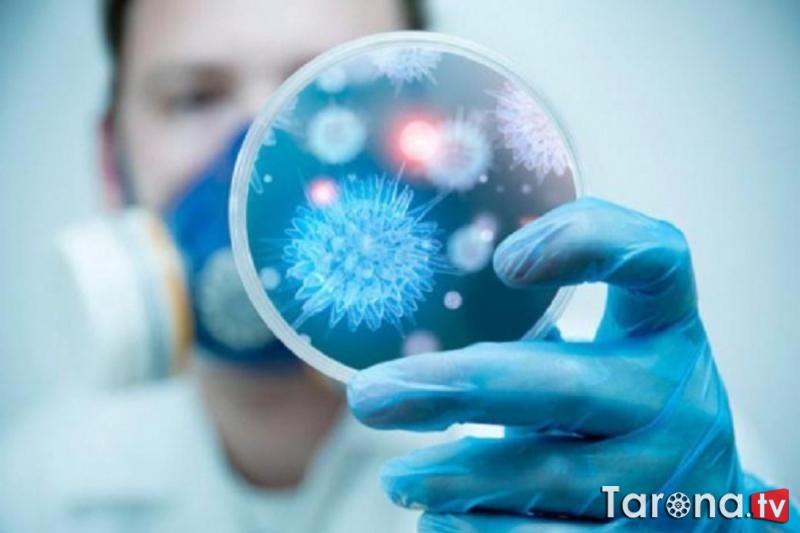

10:14 Koronavirusda taqiqlangan meva | |
 Koronavirusdan davolanayotganda greypfrut iste’mol qilmaslik kerak. Shuningdek, onkologik va kardiologik kasalliklardan qiynalayotgan bemorlarga ham bu meva taqiqlanadi, dedi rossiyalik diyetolog Anna Belousova. «Koronavirusni davolash paytida, haqiqatan ham, greypfrut tavsiya etilmaydi. Xolesterin darajasini kamaytiradigan dorilarni qabul qilayotganlarga ham, aterosklerozdan davolanayotganlarga ham ushbu mevani iste’mol qilish qat’iyan man etiladi», — dedi mutaxassis gap mevaning o‘zi va sharbati haqida ketayotganini alohida ta’kidlab. Mutaxassisning so‘zlariga ko‘ra, tinchlantiruvchi va onkologik kasalliklarga qarshi dorilar yo‘riqnomasida ularni birgalikda qabul qilib bo‘lmaydigan mahsulotlarning to‘liq ro‘yxati keltirilgan. Ushbu taqiq mazkur dorilar tarkibidagi neyrogenin moddasi bilan izohlanadi. Greypfrut bilan qo‘shilganda preparatning ta’siri kamayishi mumkin, shuningdek, kutilmagan oqibatlarga olib kelishi hech gap emas.
Manba: "xabar.uz"
| |
|
| |